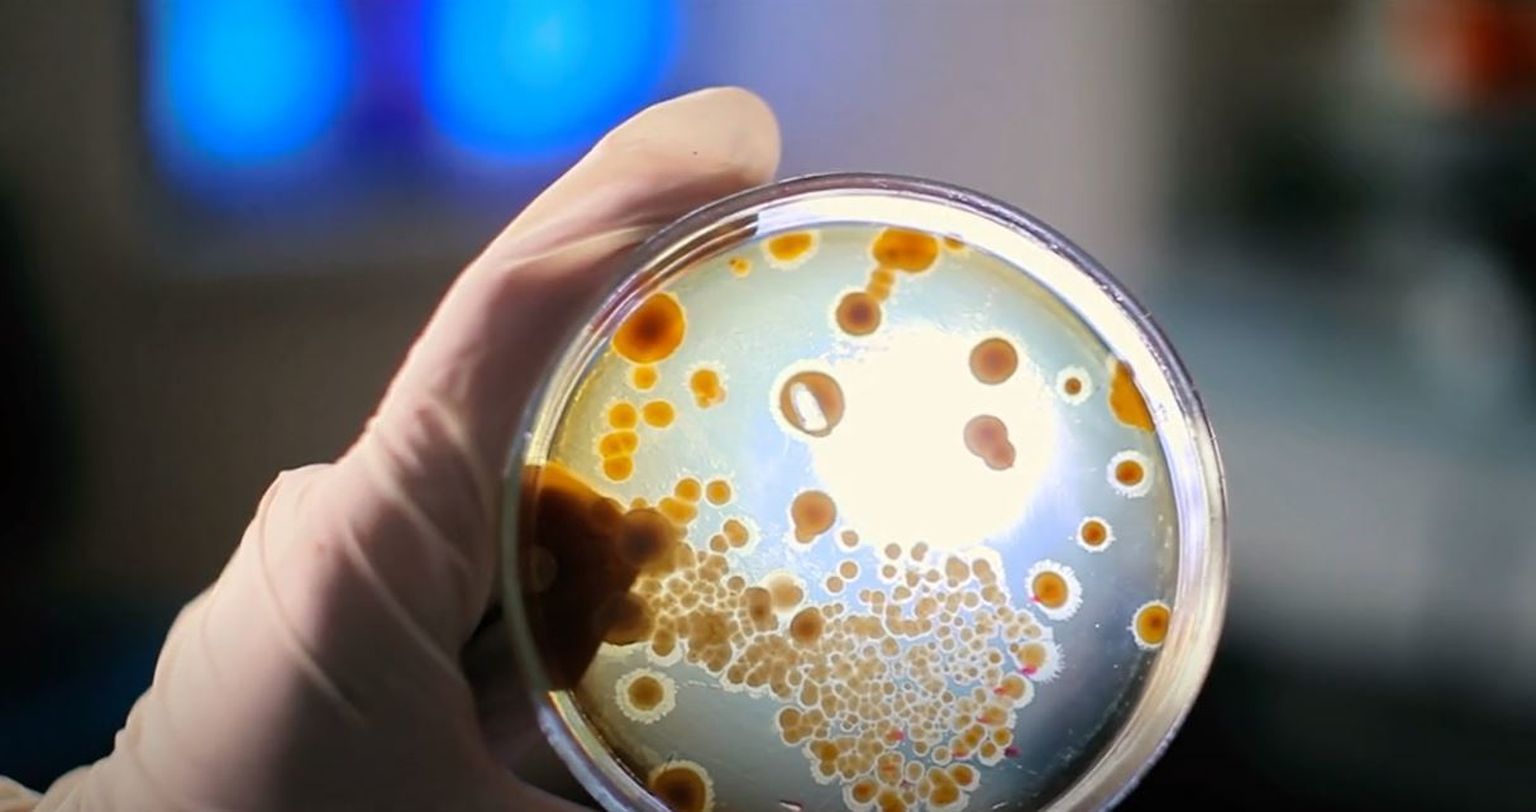

-
 Koronavirus, Hrvatska, ilustracija - 3 Foto: DNEVNIK.HR
Koronavirus, Hrvatska, ilustracija - 3 Foto: DNEVNIK.HR -
Koronavirus, ilustracija Foto: DNEVNIK.hr
Koronavirus, ilustracija Foto: DNEVNIK.hr -
 Koronavirus - Iskustva preboljelih - 9 Foto: DNEVNIK.hr
Koronavirus - Iskustva preboljelih - 9 Foto: DNEVNIK.hr -
 Koronavirus, Hrvatska, Ilustracija - 2 Foto: DNEVNIK.HR
Koronavirus, Hrvatska, Ilustracija - 2 Foto: DNEVNIK.HR -
 Koronavirus, Hrvatska, ilustracija - 1 Foto: DNEVNIK.HR
Koronavirus, Hrvatska, ilustracija - 1 Foto: DNEVNIK.HR -
 Koronavirus, Hrvatska, Ilustracija - 6 Foto: DNEVNIK.HR
Koronavirus, Hrvatska, Ilustracija - 6 Foto: DNEVNIK.HR -
Pogledaj i ovo



 +
1
+
1

HRVATSKA IZ MINUTE U MINUTU
U Hrvatskoj zaraženo još 29 osoba, preminulo troje oboljelih: U jednoj županiji raste broj hospitaliziranih

HRVATSKA IZ MINUTE U MINUTU
Nije dobro! Zabilježeno čak 677 novih slučajeva, preminule četiri osobe. U jednoj županiji pozitivan svaki drugi testirani

HRVATSKA IZ MINUTE U MINUTU
Pada postotak pozitivnih među testiranima, preminula 51 osoba: U jednoj županiji prošlog mjeseca cijepili rekordan broj stanovika

